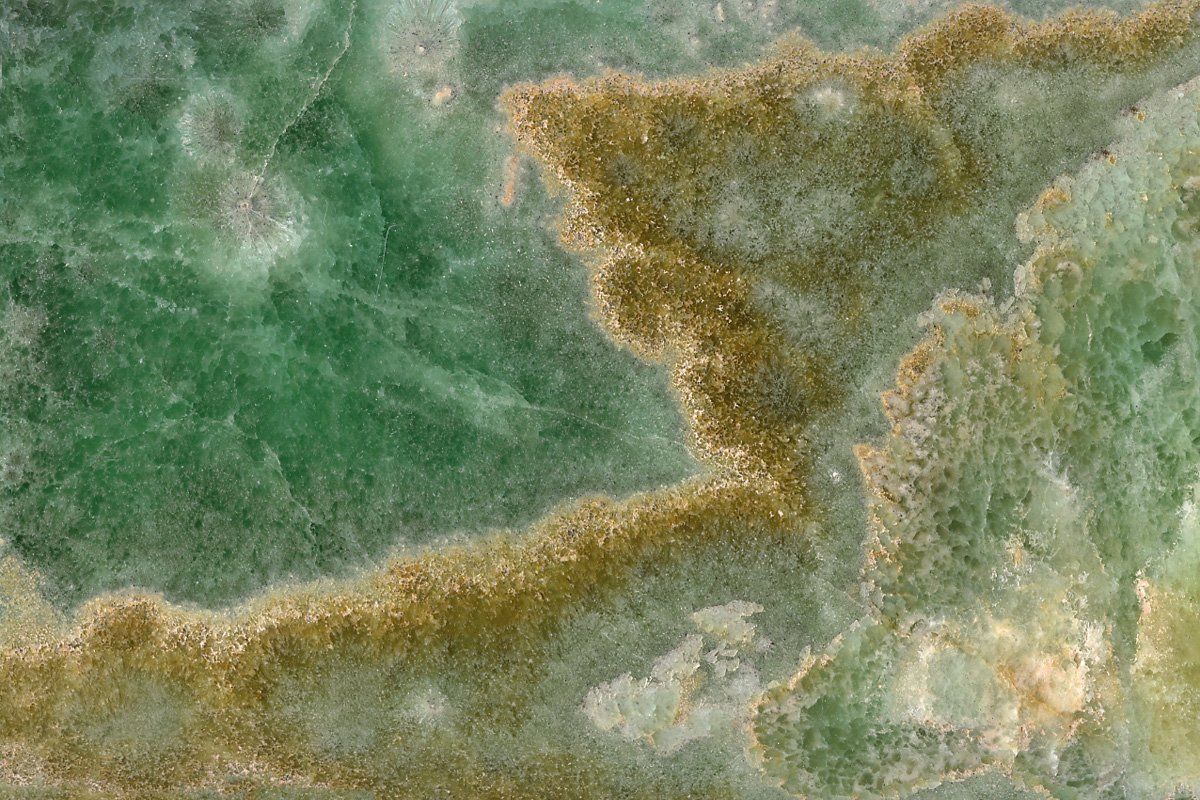
Onice Smeraldo

Fornitura di pietre e travertino a livello internazionale
Scegliere i servizi offerti dall’azienda Marmi di Carrara vuol dire assicurarsi solo il meglio delle lavorazioni per cura dei dettagli e selezione dei materiali. In particolar modo quest’ultimo aspetto caratterizza da ormai oltre mezzo secolo l’azienda carrarese, che pone particolare attenzione alla scelta dei materiali per garantire prodotti finali duraturi nel tempo e qualitativamente impeccabili. Tra i materiali commercializzati e usati nei progetti rientrano:
Contatti
- Marmi
- Graniti
- Travertini
- Onici
- Pietre
Per informazioni e preventivi gratuiti non esitate a chiamare oggi stesso.